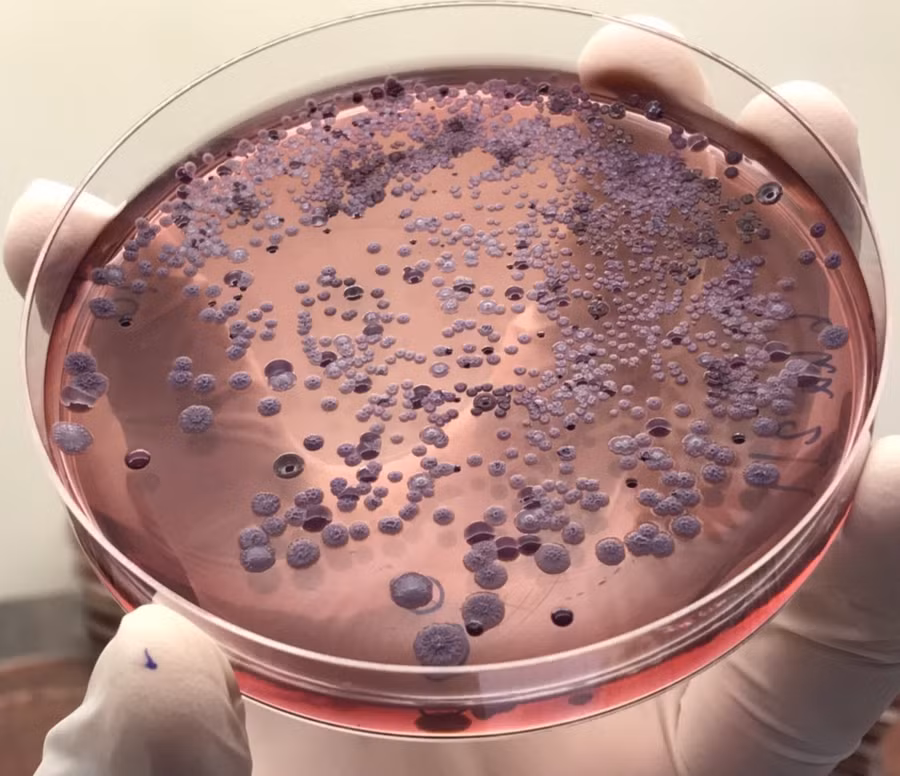
burkholderia-pseudomallei-colonies-isolated-from-soil-in-thailand.jpg

Ukraine dồn dập tập kích hạ tầng dầu mỏ và quân sự của Nga
Đêm 17 rạng sáng 18-4, lực lượng Ukraine đã tập kích các nhà máy lọc dầu Novokuibyshevsk và Syrzan ở tỉnh Samara, một nhà ga dầu tại Khu phức hợp phân phối và trung chuyển Vysotsk Lukoil-2 ở tỉnh Leningrad và trạm bơm dầu Tikhoretsk ở vùng Krasnodar, gây ra hỏa hoạn tại các cơ sở này.
Các quan chức khu vực của Nga thừa nhận rằng các cuộc tập kích của Ukraine bằng máy bay không người lái (UAV) đã gây ra hỏa hoạn tại cảng ở Vysotsk, tỉnh Leningrad và tại một kho dầu gần Tikhoretsk, vùng Krasnodar.

Cũng trong ngày 18-4, Cơ quan An ninh Ukraine (SBU) báo cáo rằng lực lượng Ukraine cũng đã tấn công các mục tiêu quân sự và năng lượng ở Crimea, bao gồm tàu đổ bộ lớn lớp Yamal và Azov Ropucha dự án 775, một tàu chiến thứ ba không xác định, khối ăng-ten của hệ thống liên lạc Delfin và trạm radar MMys-M1 ở các khu vực không xác định của Crimea, và các bể chứa nhiên liệu tại kho dầu Yugtorsan gần Sevastopol.
SBU cho biết, các cuộc tấn công của Ukraine cũng có thể đã làm hư hại một tàu tuần tra lớp Grachonok dự án 21980 của Nga.
Israel lập “Đường Vàng” tại Liban
Quân đội Israel (IDF) thông báo đã thiết lập một ranh giới phân định mới mang tên “Đường Vàng” tại miền Nam Liban, trong khi phong trào Hezbollah tuyên bố lệnh ngừng bắn không thể mang tính một phía và sẽ đáp trả nếu bị tấn công.

Trong tuyên bố ngày 18-4, IDF cho biết lực lượng của họ đã hoạt động ở phía Nam “Đường Vàng”, một ranh giới quân sự mới được thiết lập tương tự cơ chế phân tách tại Dải Gaza, và phát hiện các tay súng bị cáo buộc là “phần tử khủng bố” vi phạm thỏa thuận ngừng bắn khi tiếp cận khu vực từ phía Bắc ranh giới này. Theo IDF, các hành động quân sự đã được tiến hành nhằm “loại bỏ mối đe dọa tức thời”, nhấn mạnh những biện pháp tự vệ này không bị hạn chế bởi lệnh ngừng bắn.
Việc thiết lập “Đường Vàng” được công bố chỉ hai ngày sau khi Israel và Liban đạt thỏa thuận ngừng bắn kéo dài 10 ngày (từ 16-4) nhằm tạo điều kiện cho các cuộc đàm phán chấm dứt cuộc xung đột kéo dài 6 tuần giữa Israel và lực lượng Hezbollah.
Hàn Quốc huy động 5 trực thăng chữa cháy rừng tại tỉnh Gyeongsang Bắc
Các lực lượng chức năng Hàn Quốc đang khẩn trương triển khai công tác chữa cháy sau khi một vụ hỏa hoạn bùng phát trên khu vực đồi núi thuộc tỉnh Gyeongsang Bắc vào sáng 19-4.

Khoảng 10h35 theo giờ địa phương (tức 8h35 cùng ngày theo giờ Việt Nam), đám cháy bùng phát lan rộng bắt nguồn từ một ngọn đồi ở làng Ogi-ri, xã Subi, huyện Yeongyang của tỉnh Gyeongsang Bắc, cách thủ đô Seoul khoảng 290km về phía Đông Nam.
Ngay sau khi nhận được tin báo, chính quyền địa phương đã thiết lập tình trạng khẩn cấp, điều động lực lượng phản ứng nhanh gồm 70 nhân viên cứu hỏa và lực lượng kiểm lâm chuyên trách với 5 trực thăng chữa cháy chuyên dụng cùng 23 thiết bị, bao gồm xe cứu hỏa và các phương tiện hỗ trợ mặt đất.
Hiện chưa có báo cáo về thiệt hại về người. Cơ quan chức năng đang nỗ lực dập tắt hoàn toàn ngọn lửa trước khi gió mạnh có thể khiến tình hình phức tạp hơn. Nguyên nhân vụ cháy sẽ được điều tra làm rõ sau khi công tác dập lửa hoàn tất.
Trung Quốc triệt phá đường dây sản xuất, tiêu thụ rượu giả quy mô lớn
Lực lượng quản lý thị trường và công an hai tỉnh Sơn Tây, Tứ Xuyên (Trung Quốc) vừa triệt phá một mạng lưới tội phạm sản xuất và tiêu thụ rượu trắng giả, kém chất lượng, xâm phạm nhãn hiệu.

Trong quá trình điều tra, lực lượng chức năng Trung Quốc đã đồng loạt khám xét 7 địa điểm tại thành phố Lữ Lương và Thái Nguyên, tỉnh Sơn Tây, gồm các cơ sở sản xuất, cất giấu hàng hóa, đóng gói, in ấn nhãn mác và chuyển phát sản phẩm vi phạm. Ngoài ra, một điểm bán hàng qua hình thức livestream cũng bị phát hiện và xử lý.
Tang vật thu giữ gồm gần 20.000 thùng rượu trắng giả, hơn 700.000 bộ bao bì, tem nhãn giả, 14 thiết bị phục vụ việc sản xuất hàng giả cùng 41 bồn chứa rượu cỡ lớn. Giới chức Trung Quốc cho biết đây là một trong những vụ việc điển hình, có quy mô lớn trong lĩnh vực xâm phạm nhãn hiệu hàng hóa thời gian gần đây.
Thái Lan ban hành cảnh báo bệnh Whitmore sau khi ghi nhận 23 ca tử vong
Ngày 18-4, giới chức Thái Lan phát đi cảnh báo kêu gọi người dân nâng cao cảnh giác đối với bệnh Whitmore, trong bối cảnh dịch bệnh diễn biến phức tạp từ đầu năm 2026 đến nay. Từ tháng 1 - tháng 4/2026, nước này đã ghi nhận 732 ca mắc bệnh Whitmore, trong đó có 23 trường hợp tử vong.
Theo số liệu được công bố, bệnh Whitmore hiện xuất hiện phổ biến nhất tại khu vực Đông Bắc Thái Lan. Văn phòng kiểm soát dịch bệnh khu vực số 7 (phụ trách các tỉnh Khon Kaen, Maha Sarakham, Roi Et và Kalasin) đã ghi nhận 68 ca mắc bệnh và 2 trường hợp tử vong từ đầu năm tới nay. Trong đó, nhóm người từ 50 tuổi trở lên có tỷ lệ mắc bệnh cao nhất.
Bộ Y tế Thái Lan đánh giá diễn biến dịch bệnh ở mức đáng lo ngại và đang theo dõi sát tình hình.























































